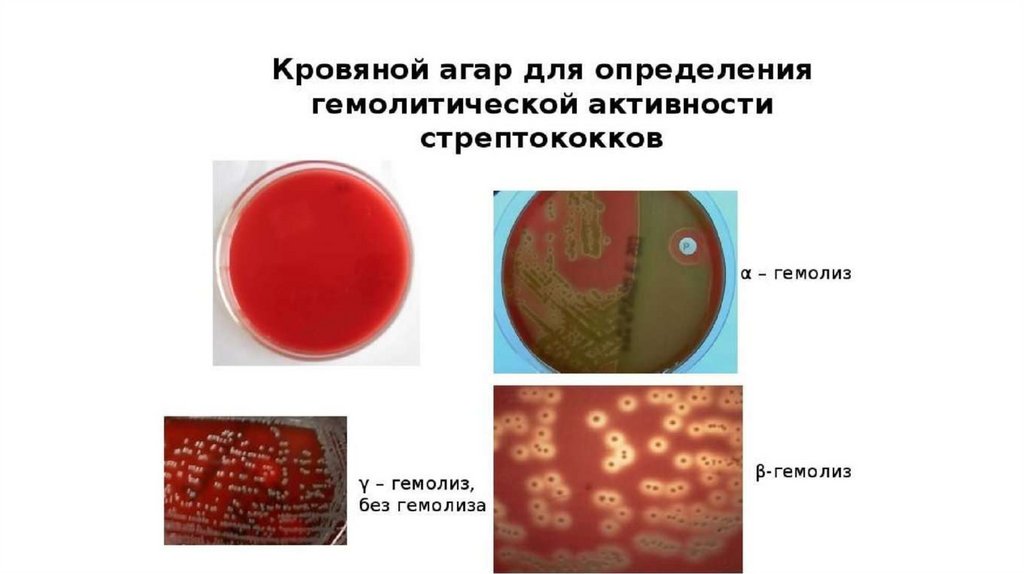
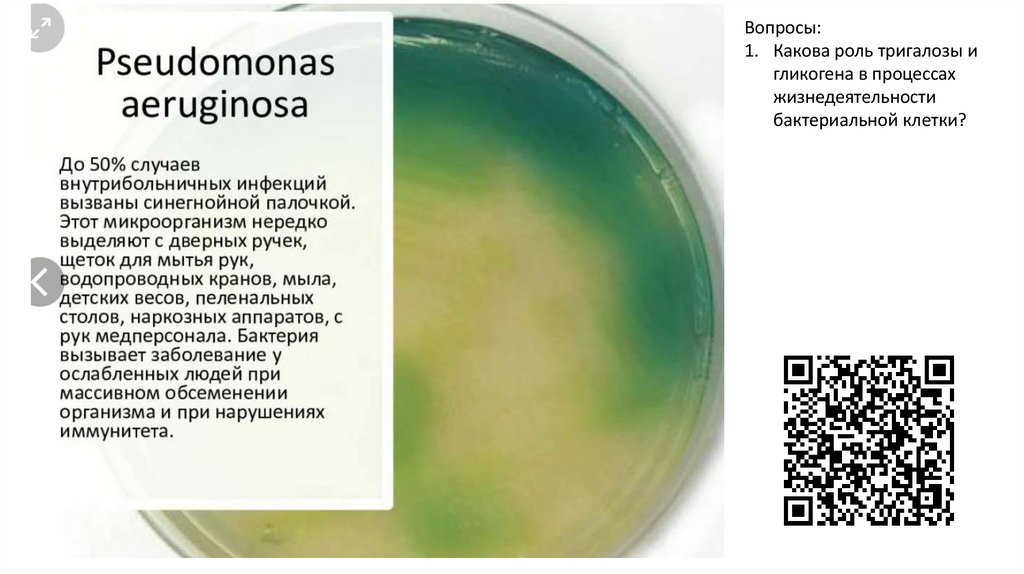

Similar presentations:
Внутрибольничные инфекции
1.
Внутрибольничныеинфекции
Андреева Екатерина Анатольевна
2.
Внутрибольничной инфекцией (ВБИ) называют любое инфекционноезаболевание, заражение которым произошло в условиях лечебного
учреждения.
[от греч. nosokomeion, больница]
[от греч. iatros, врач]
Виды ВБИ
Заболевания,
полученные в
стационарах
При
поликлинической
помощи
Заболевания
медицинских
работников при
оказании помощи
3.
Угроза жизни больногоУвеличение стоимости
лечения
4.
Причины развития ВБИ:Формирование
и
селекция
«госпитальных
штаммов»
микроорганизмов,
обладающих
высокой
вирулентностью
и
множественной лекарственной устойчивостью;
• Нерациональное проведение антимикробной химиотерапии и
отсутствие контроля за циркуляцией штаммов с лекарственной
устойчивостью.
• Значительная частота носительства патогенной микрофлоры
(например, золотистого стафилококка) среди медицинского персонала
(достигает 40%).
• Создание крупных больничных комплексов со своей специфической
экологией - скученностью в стационарах и поликлиниках,
особенностями основного контингента (преимущественно ослабленные
пациенты), относительной замкнутостью помещений (палаты,
процедурные кабинеты и т.д.).
• Нарушения правил асептики и антисептики, отклонения от санитарногигиенических норм для стационаров и поликлиник.
5.
Как правило, возникают на фоне основногозаболевания, реже первично (у
новорождённых)
Особенности ВБИ
Может вызвать практически любой
патогенный или условно-патогенный
микроорганизм
Возбудители ВБИ могут передаваться
воздушно-капельным, воздушно-пылевым,
алиментарным путями, трансфузионно,
трансплацентарно, при прохождении плода
по родовым путям, половым и другими
способами.
6.
Группы риска по заражению ВБИ• Новорожденные;
• Пожилые люди;
• Истощенные;
• Больные с хронической патологией (сахарный диабет, сердечная
недостаточность, злокачественные опухоли);
• Длительно получающие антибиотики и антацидные средства
(снижающие кислотность желудочного сока);
• ВИЧ-инфицированные;
• Люди, прошедшие курс химио-/лучевой терапии;
• Пациенты после инвазивных манипуляций;
• Больные с ожогами;
• Алкоголики.
7.
ЗаболеваемостьВБИ
Вспышечная
(несколько
случаев)
Спорадическая
(единственный
случай)
Заболевших связывает нахождение в одном помещении, применение общего
инструментария, совместное употребление больничной пищи, использование
общей санитарной комнаты. Сезонность у вспышек отсутствует, они
регистрируются в любое время года.
8.
Актуальность проблемыВБИ в стоматологии
Массовость
стоматологической
помощи
Обслуживание пациентов
без предварительного
обследования на
инфекционные
заболевания
В ротовой полости
представители не только
резидентной микрофлоры,
но и патогенные
представители
Поэтому всех пациентов необходимо рассматривать как
потенциально инфицированных, в том числе и ВИЧинфекцией.
9.
«Безобидные» бактерии ротовой и носовойполостей могут быть причиной
внутрибольничных
инфекций
Вопросы и задания:
1. Бактерии какого рода были включены в
указанное исследование?
2. Каким образом на указанный
микроорганизм влияли ИВЛ и
парентеральное питание у пациента?
3. Почему описанные микроорганизмы
обладают высоким адаптивным
потенциалом?
10.
опасные микроорганизмы с множественной устойчивостьюк антибиотикам
ESKAPE
Enterococcus
faecium
Staphylococc
us aureus
• Грам+
• Представитель условнопатогенной флоры
• Некторые штаммы – в
пищевой промышленности,
некоторые бактериальный
перитонит
Klebsiella
pneumoniae
Acinetobacter
baumannii
Pseudomona
s aeruginosa
• Грам• Синегнойная
• Колонизирует
палочка
ЖКТ,
• Грамвлагалище,
уретру
НО! Причина
нозокомиальных
пневмоний,
сепсиса, абсцесса,
остеомиелита итд
Enterobacter
spp
• Грам• Колонизирует
ЖКТ
• Причина ВБИ
11.
Способствуют ли кофемашиныраспространению ВБИ?
12.
Проверим себя!https://learningapps.org/watch?v=pux5fin5524
13.
Санобработка моющим средством спробиотиками снижает частоту
внутрибольничных инфекций
Вопросы и задания:
• Какие бактерии
предлагается использовать
вместе с детергентами?
• Почему указанный метод
обработки может не
прижиться в больницах
нашего города?
14.
Возбудители госпитальных инфекций• Вирусы, бактерии, грибы и простейшие;
• Штаммы наиболее вирулентные, обладают множественной
химиорезистентностью;
• Число увеличивается преимущественно за счет условнопатогенных представителей;
• Ведущую роль играют стафилококки (до 60% всех случаев ВБИ),
грамотрицательные бактерии, респираторные вирусы и грибы
рода Candida.
• Клиническая картина часто стёртая (атипичная)
• Проявления у стационарных больных, как правило, более
тяжёлые, чем у амбулаторных пациентов с аналогичными
инфекциями
15.
грибы рода Candida• Заболевание – кандидоз
• Поражение слизистых оболочек, кожи, внутренних органов
(висцеральный кандидоз), Candida-сепсис
• 6–10 мкм
• Частота носительства грибов рода Candida у здоровых лиц
достигает в полости рта 25 %, в кишечнике — до 65–80 %
• Благоприятная темп. - 21–37 °С и кислотность среды 5,8–6,5
рН.
• Носительство в ротовой полости:
- C. Albicans (47-75%)
- C. Tropicalis
- C. globrata
• Сухость, сжение слизистой оболочки рта;
• У молодых людей большое количество творожестых масс
определяется на языке (наличие на спинке языка сосочковрецепторов, механически затрудняющих удаление налёта)
• У пациентов, пользующихся съёмными протезами, налёт
определяется, прежде всего, в местах протезионного ложа
Вопросы для
самостоятельного
рассмотрения:
1. Происхождение названия
указанного патогена
2. Чем обусловлен рост
числа случаев
заболевания?
3. Какие факторы
увеличивают процент
носительства кандид?
16.
Диагностика:- Микроскопическое исследование
- ИФА
Характерен диморфизм
- ПЦР
Дрожжевая фаза
(бластоспоры)овальные
клетки
Мицелиальная фаза
(палочковидные клетки)
17.
АдгезиныФакторы
патогенности
Ферменты
агрессии
(фосфолипазы,
протеазы)
Олигосахариды
клеточной стенки
(ингибируют
иммунные
реакции)
18.
СтафилококкиНаиболее известны:
Стафилококк золотистый (Staphylococcus aureus), как
наиболее патогенный для человека. Назван по способности
образовывать золотистый пигмент. Может вызывать у человека
гнойные воспалительные процессы почти во всех органах и тканях.
Стафилококк эпидермальный (Staphylococcus epidermidis) —
часто встречается на коже и слизистых оболочках человека, может
вызывать сепсис, эндокардит, конъюнктивит, гнойную инфекцию
ран и гнойные инфекции мочевыводящих путей.
Стафилококк сапрофитный (Staphylococcus saprophyticus) —
может вызывать острый цистит и уретрит.
19.
20.
СтафилококкиМорфологические свойства: Все виды стафилококков представляют собой округлые клетки. В мазке
располагаются несимметричными гроздьями. Клеточная стенка содержит большое количество
пептидогликана, связанных с ним тейхоевых кислот, протеин А. Грамположительны. Спор не образуют,
жгутиков не имеют. У некоторых штаммов можно обнаружить капсулу.
Условно – патогенные
Адгезины
Защищает от
фагоцитоза
Ферменты
агрессии
Капсула
Факторы
патогенности
Каталаза –
защищает от
фагоцитов
Лактамаза –
разрушает молекулы
антибиотиков
21.
ДиагностикаСерологический метод
Бактериоскопический метод: из исследуемого материала
(кроме крови) готовят мазки, окрашивают по Граму.
Наличие грам «+» гроздевидных кокков, располагающихся
в виде скоплений.
Бактериологический метод: посевы на селективных средах
ПЦР
https://yandex.ru/video/preview/13186973474959507811
22.
Staphylococcus aureus• Чаще всего колонизирует носовые ходы, подмышечные области;
• Хроническое носительство типично для персонала медицинских учреждений,
больных атопическими дерматитами, наркоманов.
• После госпитализации носителями, в основном больничных штаммов
золотистых стафилококков, становится 20–30 % пациентов
• Некоторые штаммы золотистого стафилококка приобрели резистентность к
широкому кругу антибиотиков, в частности к пенициллинам (метициллин,
диклоксациллин, нафциллин, оксациллин и т.д.) и цефалоспоринам. Эти
штаммы, называющиеся метициллин-резистентые (или
метициллинрезистентые, или MRSA )
23.
СтрептококкиВиды:
Streptococcus pyogenes (прежнее название Streptococcus haemolyticus) —
бета-гемолитические стрептококки группы А.
Streptococcus pneumoniae — объединяют в группу пневмококковых
инфекций.
Streptococcus faecalis, Streptococcus faecies — стрептококк группы D,
которые обычно объединяются в группу энтерококков, вызывают
септические процессы;
• Streptococcus sanguis, Streptococcus salivarius, Streptococcus mitis,
Streptococcus mutans — гемолитические и негемолитические стрептококки
24.
Морфологические и культуральные свойства. Стрептококки — это мелкиешаровидные клетки, располагающиеся цепочками, грамположительные, спор не
образуют, неподвижные. Большинство штаммов образует капсулу, состоящую из
гиалуроновой кислоты.
По характеру
роста на кровяном
агаре
а-гемолитические
(зеленящие)
в-гемолитические
(полный гемолиз)
негемолитические
25.
26.
Факторы патогенности стрептококков• На основе полисахаридного антигена делятся на серогруппы (А, В, С...О).
• Стрептококки группы А вырабатывают более 20 веществ, обладающих
антигенностью и агрессивностью.
• На поверхности клетки имеется белковый антиген М, который тесно связан с
вирулентностью (препятствует фагоцитозу). Этот белок определяет типовую
принадлежность стрептококков.
• Наиболее патогенны для человека гемолитические стрептококки группы А,
называемые S. pyogenes. Этот вид вызывает у человека многие болезни:
скарлатину, рожу, ангину, острый эндокардит, послеродовой сепсис,
хронический тонзиллит, ревматизм.
27.
Синегнойная палочка - Pseudomonasaeruginosa
• грамотрицательные аэробные
неспорообразующие бактерии
• Синегнойная палочка иногда
встречается на коже паховых и
подмышечных областей, в наружном
слуховом проходе, верхних
дыхательных путях и толстой кишке
здоровых людей.
• Синегнойная палочка обитает в
почве, воде, на растениях. Она очень
устойчива к воздействию многих
дезинфицирующих средств и может
размножаться в их слабых растворах,
а также в дистиллированной воде.
28.
Вопросы:1. Какова роль тригалозы и
гликогена в процессах
жизнедеятельности
бактериальной клетки?
29.
Клостридии диффициле (лат. Clostridioidesdifficile)
• грамположительные спорообразующие строго
анаэробные бактерии, по форме представляющие
собой большие удлиненные палочки с выпуклостью в
середине. Clostridioides difficile способны длительное
время сохраняться во внешней среде. Его споры
устойчивы к тепловой обработке.
• Clostridioides difficile обладает природной
устойчивостью к большинству антибиотиков.
• Токсикогенные штаммы Clostridioides
difficile продуцируют несколько патогенных факторов.
Наиболее изученными среди них являются: токсин А
(энтеротоксин), токсин B (цитотоксин), белок,
угнетающий перистальтику кишечника
30.
Газовая гангрена(клостридиальный некроз мышц)
1.
2.
3.
4.
5.
6.
возбудителем является анаэробная бактерия Clostridium perfringens, а также
несколько других видов клостридий.
Гр+ палочки, образуют споры, капсулы, анаэробные
Обладают высокой ферментативной активностью, расщепляют углеводы с
образованием кислоты и газа; проявляют гистолитическую активность.
Факторы патогенности: Клостридии газовой гангрены образуют экзотоксин — атоксин, являющийся лецитиназой, а также гемолизины, коллагеназу,
гиалуронидазу и ДНКазу. Экзотоксины специфичны для каждого вида
клостридий.
Резистентность. Чувствительны к кислороду, солнечному свету, высокой
температуре, дезинфектантам. Возбудители газовой гангрены, являясь
нормальными обитателями кишечника животных и человека, с фекалиями
попадают в почву, где споры длительное время сохраняются. В некоторых почвах
клостридии могут размножаться.
Эпидемиология. При тяжелых травмах и несвоевременной хирургической
обработке ран. В эпидемиологии газовой гангрены большое значение имеет
загрязнение ран почвой.
31.
Попаданиемикробов в
рану
Ассоциация
нескольких
анаэробов
Патогенез
Снижение
резистентности
Наличие
некротичес
ких тканей
Условия гипоксии
32.
• В некротических тканях анаэробы часто находят условиягипоксии, благоприятные для их размножения. Образуемые ими
токсины и ферменты приводят к повреждению здоровых тканей и
тяжелой общей интоксикации организма; а-токсин, лецитиназа,
расщепляет лецитин — важный компонент клеточных мембран.
Выделяемые гиалуронидаза и коллагеназа увеличивают
проницаемость тканей, а также способствуют распространению
микроба в окружающей ткани.
• Клиника. Инкубационный период короткий — 1—3 дня. Отеки,
газообразованием в ране, выраженной интоксикацией
организма. Течение болезни усугубляют сопутствующие бактерии.
• Гнилостный запах
33.
34.
Гипербарическая оксигенацияВыполним задание:
35.
Домашнее задание1. Подготовиться к письменной контрольной работе по следующим
вопросам (материалами лекции не пользуемся):
1) Знать определения: внутрибольничная инфекция, нозокомиальная
инфекция, ятрогения
2) Почему ВБИ является значимой проблемой здравоохранения?
3) Причины развития ВБИ
4) Группы риска по заражению ВБИ
5) Вспышечная заболеваемость ВБИ (определение), спорадическая
заболеваемость ВБИ
6) ESKAPE (понятие, перечислить микроорганизмы, которые входят в данную
группу, их краткая храктеристика)
7) Знать характеристику (только в пределах лекции!) следующих
микроорганизмов: Candida, Стафилококки, стрептококки, синегнойная
палочка, клостридии диффициле
8) Газовая гангрена

medicine
medicine








